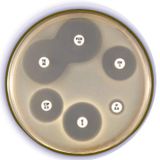

M.I.C.Evaluator Strips
For the determination of antimicrobial susceptibility MIC values
Description
The M.I.C.Evaluator™ (M.I.C.E.™) strips are a range of devices for the accurate determination of the minimum inhibitory concentration (MIC) of a test organism to an antimicrobial. The M.I.C.E. strips consist of a gradient of stabilised antimicrobial covering 15 doubling dilutions. The innovative new design makes the clinical interpretation of the MIC even easier by removing the half step values. The accuracy of the test is still maintained if required using the black sections on the strip.
On application of a M.I.C.E. strip to a pre-inoculated agar plate, the antimicrobial releases from the polymer strip, forming a defined concentration gradient in the area around it. After appropriate incubation, growth develops with a zone of inhibition around the strip. The large print font makes MIC is easy to read, as the value in the section where the growth first touches the strip. For full reading instructions please refer to the M.I.C.Evaluator Reading Guide (309KB) in PDF format. If interpretational criteria are required, please refer to local guidelines or see EUCAST recommendations.
Each M.I.C.E. strip is individually sealed in an easily peelable sachet with a desiccant to maintain the long term stability of the product. When the sachet is opened, the handle of the M.I.C.E. strip is conveniently presented, allowing easy placement of the strip on the agar plate. The sachets are presented in an easily stackable, durable box, which protects the strips from physical damage during transportation. M.I.C.E. strips are available in packs of 10 and 50 to allow maximum flexibility to meet your requirements.
M.I.C.E. strips allow for the rapid and accurate determination of the MIC of an organism to an antibiotic which can significantly improve patient management.
The M.I.C.E. range includes:
Antimicrobial | Antimicrobial | Concentration | Product code | Pack | Product code | Pack |
Amikacin | AK | 256–0.15 | MA0135D | 10 | MA0135F | 50 |
| Amoxycillin | AML | 256–0.015 | MA0109D | 10 | MA0109F | 50 |
| Amoxycillin/clavulanic acid | AMC | 256–0.015 | MA0107D | 10 | MA0107F | 50 |
| Ampicillin | AMP | 256–0.015 | MA0110D | 10 | MA0110F | 50 |
| Cefotaxime | CTX | 32–0.002 | MA0111D | 10 | MA0111F | 50 |
| Cefotaxime | CTX | 256–0.015 | MA0112D | 10 | MA0112F | 50 |
| Ceftaroline | CPT | 32–0.002 | MA0127D | 10 | MA0127F | 50 |
| Ceftazidime† | CAZ | 256–0.015 | MA0120D | 10 | MA0120F | 50 |
| Ceftriaxone | CRO | 32–0.002 | MA0122D | 10 | MA0122F | 50 |
| Ciprofloxacin | CIP | 32–0.002 | MA0104D | 10 | MA0104F | 50 |
| Clindamycin | DA | 256–0.015 | MA0119D | 10 | MA0119F | 50 |
| Daptomycin | DAP | 256–0.015 | MA0125D | 10 | MA0125F | 50 |
| Erythromycin | E | 256–0.015 | MA0108D | 10 | MA0108F | 50 |
| Gentamicin | CN | 256–0.015 | MA0116D | 10 | MA0116F | 50 |
| Gentamicin | CN | 1024–0.06 | MA0117D | 10 | MA0117F | 50 |
| Imipenem | IPM | 32–0.002 | MA0115D | 10 | MA0115F | 50 |
| Levofloxacin | LEV | 32–0.002 | MA0113D | 10 | MA0113F | 50 |
| Linezolid | LZD | 256–0.015 | MA0106D | 10 | MA0106F | 50 |
| Meropenem | MEM | 32–0.002 | MA0121D | 10 | MA0121F | 50 |
| Metronidazole | MTZ | 256–0.015 | MA0103D | 10 | MA0103F | 50 |
| Oxacillin | OX | 256–0.015 | MA0114D | 10 | MA0114F | 50 |
| Penicillin G | P | 32–0.002 | MA0100D | 10 | MA0100F | 50 |
| Penicillin G | P | 256–0.015 | MA0101D | 10 | MA0101F | 50 |
| Teicoplanin | TEC | 256–0.015 | MA0118D | 10 | MA0118F | 50 |
| Tetracycline | TE | 256–0.015 | MA0105D | 10 | MA0105F | 50 |
| Tigecycline | TGC | 256–0.015 | MA0124D | 10 | MA0124F | 50 |
| Vancomycin | VA | 256–0.015 | MA0102D | 10 | MA0102F | 50 |
† only available in selected territories
Additional information on the use and interpretation of M.I.C.Evaluator strips can be obtained by simply downloading the M.I.C.Evaluator Interpretation Guide (912KB) in PDF format; M.I.C.Evaluator datasheet (2.6MB) in PDF format; the M.I.C.Evaluator Monograph (4.3MB) in PDF format; or the M.I.C.Evaluator multilinguage Instructions for Use (176KB) in PDF format.